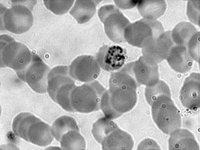
Plasmodium 1000x  eukaryotic cells, parasite : eukaryotic cells, parasite

1 Amoeba contractile vacole, cell membrane, ctyoplasm, pseudopodium, nucleus, endoplasm, ectoplasm, plasmalemma, food vacuoles, eukaryote
2 Stoma: Open and Closed stoma, chloroplast, guard cells, epidermal cells, open, closed, subsidiary, plant, gases
3 Types of Symmetry in Organisms bilateral symmetry, beetle, radial symmetry, coral polyp, no symmetry, sponge
4 Chromosomes in Meiosis replicate, pair up, homologous recombination, divide, genetic material, nucleus
5 Separation of Homologous Chromsomes gametes, chromosomes, combinations
6 Experimental Design of Effects of KDH Gas on Pea Seeds potassium hydroxide, water, phenol red, pea seens, air, gas
7 How General Spectrometry Works white light source, opaque plate, prism, spectrum, mirror, photoelectric cells, sample, %, transmittance
8 E-Coli Dish
9 TrichromeStain
10 Protostome and Deuterostome Development coelom, mesoderm, anus, archenteron, blastopore, mouth, digestive tube
11 Photosynthesis Experimental Design withElodea 2 light, photosynthesis, elodea test tube, clamp
12 Anatomical Illustration of a Wheat Stalk palea, anther stigma, lemma glume, spikelet, wheat
13 Effects of Hypertonic, Isotonic, and Hypotonic Solutions high solute, equal solute, low solute, burst shrink, remain the same, plasmolyzed, flaccid, turgid, water, red blood cells
14 Illustrations of Permeable and Selectively Permeable Membranes membanes, selectively, permeable
15 Sea Urchin Development egg, fertilization, development, invertebrate, blastomere, bastula, gastrula, pluteus, sperm
16 Plant Internodes petiole, internode, shoot, root, stem, leaves
17 Fly Life Cycle pupa, third instar larva, adult flies, egg, embryo, first instar larva, second instar larva
18 Airy Defraction Pattern airy disc, airy patters, diffraction, Rayleigh Criterion
19 Animal Cell Cytokinesis cytokinesis, animal cell, cleavage furrow, contractile ring, mitosis, meiosis
20 Cell Division: Mitosis and Meiosis DNA replication, cell division, meiotic division, homologous chromosomes, equatorial plane
21 Independent Assortment of Chromosomes chromosomes assortment, combinations, possibility, independently, gametes
22 DNA Crossover rearrangment, crossing over, meiosis
23 Cell Cycle interphase, G1 phase, G2 phase, DNA synthesis, cytokinesis, mitosis, mitotic phase
24 Gymnosperm Life Cycle gametophyte, megaspore, cone, sprorophyte, seed, egg, microspore, pollen
25 Photosynthesis Experimental Design with Elodea light, photosynthesis, elodea
26 Photosynthesis Experimental Design with Elodea 3 light, photosynthesis, elodea test tube, clamp
27 Aerobic Cellular Respiration Experiments: Germinating Peas germination, aerobic respiration, experiment, peas, respirometer
28 Karotype chromosomes size, shape, number
29 Translation ribosome, mRNA, rRNA, peptide, protein, peptide bond, anticodon, amino acid, tRNA, codon
30 Facial Traits table 2 dominant, hybrid, recessive, eyelashes, eyebrows, nose, lips, ears, mouth, freckles, dimples
31 Facial Traits table 1 dominant, hybrid, recessive, face, chin, hair, widow's peak, eyes
32 Polymerase Chain Reaction denaturation, annealing, extension, DNA
33 Types of Compound Leafs palmately, axillary bud, bipinnately, pinnately, petiole, petiolule, rachis, leaf
34 Cell Cycle-color M phase, mitosis, G2 phase, S phase, G1 phase, interphase, gap, cell division, DNA synthesis
35 Frog Incision Lines dissection, frog
36 Anatomical Illustration of a Tadpole: Dorsal and Lateral eye, mouth, intestines, heart
37 Anatomical Illustration of a Rat: Arteries carotid, subclavian, axillary, mammary, brachiocephalic, aortia arch, celiac, splenic, hepatic, gastric, renal, mesentaric, iliolumbar, genital, femoral, caudal
38 Rat Incision Muscles Marks dissection, surgery, rat
39 Anatomical Illustration of a Rat: Organs trachea, gland, thymus, atrium, lung, diaphragm, liver, pancreas, duodenum, larynx, thyroid, paratid, esophagus, heart, stomach, spleen, intestine, rectum, anus, caecum
40 Anatomical Illustration of Different Species Hearts: Fish, Amphibians, Mammals and Birds ventricle, atrium, capillary beds
41 gametophyte, megaspore, cone, sprorophyte, seed, egg, microspore, pollen
42 Anatomical Illustration of Frog and Rat Brain olfactory lobe, cerebrum, pineal gland, optic lobe, cerebellum, medulla oblongata, spinal cord
43 Anatomical Illustration of a Cockroach prothorax, wings, foreleg, midleg, hindleg, cercus, stylus, tarsus, abdomen, tibia, compound eye, coxa, femur, trochanter
44 Anatomical Illustration of a Cockroach Digestive System oesophagus, salivary gland, salivary bladder, crop, gizzard, hepatic caecae, mesenterons, rectum, colon, lleum, malpighian tubules
45 Cross Section of Bacterial Cell Walls: Gram Positive and Gram Negative outer cell membrane, peptidoglycan layer, cell membrane, lipopolysaccharides, plasma membrane, integral protein, porins, polysaccharides, teichoic acid, lipoteichoic acid
46 Anatomical Illustration of an Earthwork: Anterior End with Ventral View prostomium, mouth, setae, female aperature, male aperature, papilla, clitellum
47 Anatomical Illustration of an Earthworm: Circulatory System aortic arches, intestine, dorsal vessel, gizzard, crop, esophagus, pharynx, ventral vessel, circular muscle, longitudinal muscle
48 Anatomical Illustration of an Earthworm: Digestive System anus, intestine, gizzard, crop, pharynx, esophagus, mouth
49 Anatomical Illustration of Human Interveral Disks superiod articular process, spinous process, traverse process, vertebral foramen, anulus fibrosus, nucleus pulposus, inferior articular process, vertebral body
50 Anatomical Illustration of a Tetrahymena Vorax cytosome, cillia, macronucleus, food vacuole, contractile vacuole, polymorphic, cilliate
51 VertebralQuadrants_Labels
52 Amoeba 2 amoeba, plasmalemma, food vacuoles, ectoplasm, endoplasm, nucleus, contractile vacuole, endoplasm, pseudopodium, eukaryote
53 Anatomical Illustration of Male and Female Flies ovispositor plates, anal plates, sex comb, genital arch, penis
54 Anatmomical Illustration of a Hydra nematocyst, mouth, hypostome, tentacle, epidermis, mesoglea, testis, gastrodermis, gastrovascular cavity, bud, ovary, basal disc
55 Hyphae From Mycelium hyphae, spore, mycelium
56 Importance of Photosynthesis Experimental Design light energy, oxygen, carbon dioxide, mouse, water
57 Homogenization and Differential Centrifugation of Cells homogenization, homogenate, differential centrifugation
58 Phenotypes of Human Features ears, attached, unattached, thumb, tongue, darwin's ear point
59 Transcription and Translation gene, DNA, mRNA, codon, amino acid, protein
60 Gel Electrophoresis electrode, buffer, wire, power supply, voltage
61 Gel Electrophotels Steps comb, buffer, electrode
62 Anatomical Illustration of a Dugesia eyespot, gastrovascular cavity, auricle, pharynx
63 DNA Code
64 Dialysis Experimental Design
65 Centrafuge Concepts sedimenting material, fixed angle rotor, armored chamber, cetrifugation, pellet, supernatant, motor, vacuum, refridgeration, cell homogenate
66 Blood Pressure Cycle electrocardiogram, ECG, systolic pressure, pulse, diastolic pressure, pressure, mm of mercury, blood flow, bractial artery
67 Bacterial Cell Morphologies spirochetes, rod, bacillus, diplococci, tetrads, streptococci, staphylococci, spherical, cocci
68 Ascaris Female nematode, parasite, intestine, ovaduct, vagina, uterus, ovary
69 Anatomical Illustration of a Yellow Perch external nares, eye, mouth, operculum, pectoral fin, pelvic fin, anus, anal fin, lateral line, caudal fin, soft dorsal fin, spiny dorsal fin
70 Anatomical Illustration of a Twig of Tilia pith, cortex, cork, xylem, phloem, vascuar cambium, rays
71 Anatomical Illustration of a Tunicate: Adult and Larval atrium, gut, incurrent siphon, pharynx, excurrent siphon, nerve cord, notochord, tunic, invertebrate
72 Illustration of a Selaginell Leaf microsporangia, megasporangium, microspores, megaspores, vascular plant
73 Anatomical Illustration of a Rat: Dorsal Muscles biceps brachii, triceps brachii, latissimus dorsi, spinotrapezius, external oblique, tensor fasciae latae, gluteus maximus, biceps femoris, semitendinosus, gastrocnemius
74 Anatomical Illustration of a Male Rat: Uriniary System kidney, ureter, urinary bladder, urogenital orifice, penis, scrotal sac, adrenal gland, seminal veside, prostate gland, vas deferens, epididymus, testis
75 Anatomical Illustration of a Rat: Veins jugular, vena cava, axillary, subclavian, hepatic, renal, liver, portal, mesenteric, spienic, gastric, genital iliac, iliolumbar, caudal, femoral
76 Anatomical Illustration of a Rat: Ventral Muscles stemomastoideus, pectoralis major, biceps brachii, triceps brachii, latissimus dorsi, pectoralis minor, external oblique, rectus abdominis, linea alba, gracilis, gastrocnemius
77 Anatomical Illustration of a Jellyfish gastric cavity, radial canal, circular canal, gonad, mouth, oral arm, tentacle, rhopalium
78 Lily Ovary ovule, ovary, lily
79 Illustration of a Marchantia archegoniophore, gamma cup, liverwort
80 Anatomical Illustration of a Paramecium food vacuole, contractile vacuole, cilia, micronucleus, oral groove, macronucleus, cytostome, mouth, endoplasm, forming food vacuole
81 Anatomical Illustration of a Rhizopus sporangium, stolon, sporangiophore, rhizoids, columella, spores, fungi
82 Lichen Body Types fruticose, foliose, crustos
83 Diagram of a Lichen Cross Section upper fungal layer, algal layer, filamentous fungal hyphae, lower fungal layer
84 Bacterial Cell Morphologies 2 coccus, bacillus, spirillum
85 Blue Green Algae algae, bluegreen
86 Diatoms theca
87
88 Moss Gametophyte and Gametangia antheridium, sterile cells, sperm cells, archegonium, egg, stem, leaf
89 Equisetum Structure and Appearance 2 sporophyte, stribilus, sporangiophore, horsetail, snake grass, puzzle grass, fertile shoot, sterile shoot
90 Cnidaria Life Cycle hydranth, gonangium, medusa, testis, ovary, egg, sperm, blastula, planula, polyp, zygote, sexual, reproduction
91 Anatomical Illustration of a Prokaryotic Cell flagellum, plasmid, cytoplasm, chromosome, pili, plasma membrane, ribosomes, food granule, cell wall, capsule, bacteria
92 Animal Cell Diagram animal cell, lysosome, vacuole, centrosome, cell membrane, nucleolous, nucleus, nuclear membrane, golgi body, smooth ER, ribosomes, cytoplasm, mitrochondrion, rough ER, endoplasmic reticulum
93 Plant Cell vacuole, lysosome, centrosome, cell membrane, nucleolus, nucleus, nuclear membrane, golgi body, smooth ER, ribosomes, cytoplasm, mitochondrion, rough ER
94 Anatomical Illustration of a Yellow Perch external nares, eye, mouth, operculum, pectoral fin, pelvic fin, anus, anal fin, lateral line, caudal fin, soft dorsal fin, spiny dorsal fin
95 Anatomical Illustration of a Rat nose, vibrissae, incisors, teats, clitoris, cranial, cervical, pectoral, thorax, abdomen, pelvic, caudal, vaginal orifice, anus, scrotal sac, prepuce
96
97 Plant Mitosis interphase, prophase, metaphase, anaphase, telophase
98 Genetic Crossing Over chromatids, centromeres, non-recombinant, half recombinant, recombinant
99 Reticle measurement location, eye piece, optical device
100 Separation of Homologous Chromosomes
101 Effects of Hypertonic, Isotonic, and Hypotonic Solutions plasmolyzed, flaccid, turgid, hypertonic, isotonic, hypotonic, water, high solute, equal solute, low solute, burst, shrink, remain the same
102 Anatomical Illustration of a Frog heart artria, liver, bile duct, gall baldder, ileum, intestine, spleen, bladder, cloacal, aperture, pharnyx, esophagus, heart ventricle, stomact, dueodenum, pancreas, pylorus, cloaca
103 Diagram of a Leaf Cross Section cuticle, upper epidermis, bundle sheath parenchylla, xylem phloem, spongy mesophyll, palisade mesophyll cells, chlorophyll, guard cells, stomata, lower epidermis
104 Alveolates apicomplexa, ciliata, foraminifera, dinoflagellata, protists, alveoli
105 Ascospore Formation in Sordaria spore, fungi, ascomycota, haploid parental nuclei, fertilization, diploid, zygote, meiosis, mitosis, cytokinesis
106 Anatomical Illustration of a Clam stomach, umbo, digestive gland, hinge, heart, excretory organ, rectum, posterior adductor, muscle, anus, excurrent siphon, incurrent siphon, gill, mantle, foot, gonad, labial palps, anterior adductor muscle
107 Anatomical Illustration of a Malacostraca antennae, rostrum, cephalothorax, abdomen, telson, uropod, swimmerets, cheliped, eye
108 Asteroidea Starfish BW madraporite, radial canal, madreporite, ring canal, ampulla, tube foot
109 Asteroidea Starfish madraporite, radial canal, madreporite, ring canal, ampulla, tube foot
110 Cell Cycle BW M phase, mitosis, G2 phase, S phase, G1 phase, interphase, gap, cell division, DNA synthesis
111 Chick Embryo Labeled Diagram: 16 Hours After Fertilization mesoderm, primitive streak, ectoderm, migrating cells, endoderm, development, fertilization
112 Chick Embryo Labeled Diagram: 24 Hours After Fertilization head fold, margin of foregut, notchord, somite, neural grove, neural folds, surface ectoderm, primitive streak, development, fertilization
113 Chick Embryo Labeled Diagram: 48 Hours After Fertilization midbrain, forebrain, hindbrain eye, ear, aortic arches, heart, martin of amnion, somite, vitelline artery, spinal cord, fertilization, development
114 Anaphase: Eukaryote mitosis, meiosis
115 Anaphast Plant Cell anaphase, plant cell, mitosis, meiosis
116 Animal Embryo Development isolecithal egg, holoblastic cleavage, yolk, zygote, telocitchal egg, meroblastic cleavage, vegetal hemisphere, animal hemispehere, nucleus, blastodisc, cleavage, furrows, blastoderm, blastocoel
117
118 Ascaris Female nematode, parasite, intestine, ovaduct, vagina, uterus, ovary
119 Ascaris Male nematode, parasite
120 Ascaris External Anatomy: Male and Female anus, nematode, parasite, female gonopore, excretory pore, mouth, cloaca, penial spicules, lateral line, excretory pore
121 Organism Life Cycles animal, diploid, meiosis, zygote, fertilization, gametes, mitosis, multicellular, fungi, algae, haploid, plants, spores, gametophyte, sporophyte
122 Bean Seed, Dicot hilium, seed coat, embryo, cotyledon, dicot
123 Cell unlabeled cell
124 Cell 2 unlabeled cell
125 Cellular Respiration Experimental Design water, fermentation solution, CO2
126 Cellular Slime Mild Lifecycle asexual reproduction, sexual reproduction
127 Bacteria Cell Diagram pili, nucleoid, DNA, ribosomes, plasmid, flagella, capsule, cell wall, plasma membrane, cytoplasm, prokaryote
128 Choanocytes Labeled Diagram flagellum, food vacuole, nucleus, collar, body, ameboid cell , mesohyl, collar cells
129 Anatomical Illustration of an Amphibian anatomy, amphibian, carotid artery, subclarian artery, rena cava, dorsal aorta, coeliaco-mesenteric artery, gonad, renal vein, kidney, liliac artery, intestine, renal artery, abdominal vein, hepatic portal vein, stomach, liver, hepatic vein, lung, pulmonary artery, subclarian vein
130 Cephalopoda: Labeled Diagram arm, beak, jaw, pen, mantle, stomach, cecum, ink sac, funnel with valve
131 Chilopoda Labeled Diagram suture, legs, body segments, eye, antenna, poisonous jaws, head, centipede
132 Chilopoda Labeled Diagram suture, legs, body segments, eye, antenna, poisonous jaws, head, centipede
133 Anatomical Illustration of a Diplopoda anal segment, diplosegments , leg pairs, eye, antenna, mandible
134 Anatomical Illustration of Gastropoda (class) whorl, eye, upper tentacles, head, mouth, mantle, pneumostome, foot, shell
135 Anatomical Illustration of a Hirudinae (class) anterior sucker, mouth, genital pore, posterior sucker, anus
136 Coleus Stem Tip leaf primordia, apical meristem, provascular strand of leaf, ground meristem, primordium of axillary bud, pith, procambium, base of leaf encircling stem, protoderm, corpus, tunica
137 Corn Kernal embryo, pedicel end
138 Corn Stem Cross Section pith, herbaceous, monocot, vascular bundle
139 Anatomical Illustration of a Sunflower Stem: Cross Section vascular bundle, collenchyma cortex, phloem fibers, phloem, vascular cambium, xylem, pith, epidermis
140 Branchiostoma Cross Section dorsal fin, dorsal fin ray, nerve cord, notochord, myomere, gonad, gillslit, arterial cavity, gill bar, pharnyx, lancelet
141 Cytokinesis In Plant and Animal Cells microfilaments, cleavage furrow, daughter cells, cell plate, membrane-bounded vesicles
142 Leaf Shapes linear, lanceolate, oblong, elyptical, ovate, cordate, deltoid, spatulate, oblanceolate, obovate, obcordate, reiniform, auriculate, hastate, peltiform, cunate
143 Diffusion Experimental Design glucose solution, water, salt solution, dye solution
144 DNA Translation DNA, mRNA, protein, cytosol nuclear membrane, nuclear pore
145 Stoma: Open and Closed stoma, chloroplast, guard cells, epidermal cells, open, closed, subsidiary, plant, gases
146 Anatomical Illustration of a Dugesia dorsoventral muscle bands, ventral nerve cords, branches of gastrovascular cavity, mesenchyme, ciliated epidermis
147 Anatomical Illustration of an Egg air cell, yolk, viteline membranes, shell, membranes, germinal disk, thin albumen, chalazae, thick albulmen
148 Anatomical Illustration of an Elodea (leaf cell) nucleus, chloroplast, cell wall, vacuole, cytoplasm, waterweeds
149 Equisetum Structure and Appearance sporangiophore, sporophyte, equisetum, horsetail, snake grass, puzzle grass, fertile shoot, sterile shoot
150 Ascaris Cross Section nematode, cuticle, intestine, psuedocoel, muscle, ovary, uterus, ventral nerve cord, parasite
151 Fern Life Cycle sporophyte, gametophyte, antheridium, X.S. Sorus, spore sperm, archegonium
152 Flower Anatomy filament, anther, stamen, pistil, stigma, style, ovary, ovule, petal, sepal
153 Anatomical Illustration of a Frog amphibian, cloacal aperture, urinary bladder, cloaca, pylorus, duodenum, stomach, heart, ventricle, spleen, intestine, bile duct, esophagus
154 Frog Incision Lines dissection, frog
155 Anatomical Illustration of a Frog Heart aortae, conus arteriosus, pulmonary veins, precaval veins, atrium, sinus venosus, ventricle, postcaval vein
156 Anatomical Illustration of Frog: Muscles anconeus, deltoid, oblique, gluteus, semimembranosus, peroneus, gastrocnemium, achilles tendon, dorsi, scapulae, mylohoid, sartorius, gracilas
157 Inflorescence Types simple spike, spadix, ament, raceme, corymb, panicle, head, umbel, solitary, cyme
158 Types of Fruit dry, fleashy, legume, capsule, achene, samara, follicle, nut, caryopsis, berry, hesperidium, drupe, pome, druplets, aggregate
159 Phenotypes of Different Facial Features shape, chin shape, cleft chin, widows peak, eye shape, eye slantedness
160 Gnetum male strobilus, female cone, male cone scale, microsporangia, scales
161 Anatomical Illustration of a Grasshopper head, thorax, abdomen, forewing, hind wing, ovipositor, tarsi, tibia, spiracles, femur, walking legs, sensory palps, mouth, eye, antennae
162 Example of Hemimetabolous nymphs, adult, no larval stage
163 Example of Linnaeus Hierarchical Classification domain, kingdom, phylum, class, order, family, genus, species
164 Homogenization and Differential Centrifugation of Peas homogenization, homogenate, differential centrifugation
165 Insect and Crustacean Appendages biramous, uniramous
166 Diagram of Kernal and Seedling of Corn endosperm, pericarp, cotyledon, plumule, hypocotyl, radicle, coleorrhiza, penuncle, root, mesocotyl, coleoptile
167 Experimental Design for Mymograph of Gastrocnemis rotation, pressure, change
168 Experimental Design for Kymograph of Heart Muscle Contraction rotation, pressure, change
169 Anatomical Illustration of a Lancelet Cross Section dorsal fin, nerve cord, notochord, muscle, gill bar, gill slit, lumen of pharynx, endostyle, coelom, metapleural folds
170 Woody Stem Layers heartwood, sapwood, vascular cambium, bark
171 Types of Leaf Margins ciliate, cleft, crenate, crenulate, denate, denticulate, entire, incised, involute, lacerate, lacinate, lobed, pinnatifid, revolute, serrate, serrulate, sinulate
172 Lichen Body Types fruticose, foliose, crustos
173 Anatomical Illustration of a Lumbricus earthworm, coleum, blood vessel, nerve cord, intestine, cuticle, epidermis, peritoneum, chaetae bristles, setae
174 Lycopodium Structure strobilus, sporophyte, sporangium, sporophyl
175 Marchantia Life Cycle Antheridium, Archegonial Disc, sporophyte, antheridial disc, gametophyte, gametophite, sperm, embyro, liverworts
176 Pinus Development of Megagametophyte and Micrometophyte microspore, microspore, mother cell, pollen grains, meiosis, megasporangium, megagametophyte, egg, megasporophyte
177 Anatomical Illustration of a Metridium stromata, tentacles, actinopharynx, gastrovascular cavity, base, acontia, pedal disc, column, siphonoglyph, mouth, anemones, plumose, sea
178 Types of Muscle Tissue cardia, skeletal, smooth muscle
179 Nematode-Trapping Fungus and Victim hyphal loop, haustorium, nematode
180 Photosynthesis visible light, reflected, absorbed, energy, respiration, carbon dioxide, oxygen, water
181 Pig Venous System heart, veins, arteries
182 Pig Digestive System intestine, stomach, esophagus, mouth
183 Pig Respiratory System lungs, trachae
184 Pig Female Uro System kidney
185 Pinus, Pollen Cone, Seed Cone, and Seedling pollen cones, microsporophyl seed cone, ovule, cotyledon radicle, ovuliferous, megasporophyl, seedling, seed
186 Plant Stem Cell Comparison dicot, monocot, stem, plant
187 Plasmodium Life Cycle in Humans haploid, diploid, spores, sporangium, sporangia, plasmodium, zygote, myxamoebae, swarm cell
188 Plasmodium 1000x eukaryotic cells, parasite
189 Plasmodium 1000x2 eukaryotic cells, parasite
190 Plasmodium 1000x3 eukaryotic cells, parasite
191 Polytrichium, Life Cycle archegonium, sperm, antheridium, sperm, capsule, sporophyte, spore, gametophite, protonema
192 Preparation of An Onion Epidermis Wet Mount wet mount, epidermis, onion
193 Release of Spores From Fern Sporangium fern, reproduction, annulus, spores, lip cells
194 Bryophytes porella, mosses, spagnum, brylum, polytrichum, liverwort, merchantia, hornwort, antoceros, non-vascular, land plants
195 Respirometer With Mouse: Experimental Design soap bubble, mouse, KOH pellets, screen, respiration, oxygen, carbon dioxide
196 Effect of Respiration on pH: Experimental Design snail treatment, elodea treatment, NaOH, phenolphthalein, pH indicator
197 Respirometer In Tube respiration, wheat seeds, cotton, KOH, carbon dioxide, oxygen
198 Rhizopus Life Cycle hyphae, colony, mature sporangium, dehisced sporangium spore, germinating spore, prometangia, gametangia, zygote, zygospore, sporangium plasmogamy, fungi
199 Anatomical Illustration of a Seed and Seedling of a Bean plumule, hypocotyl, radicle, hilum, cotyledon, seed coat, micropyle, root, seed coat, epicotyl
200 Illustration of a Seed and Seedling of a Pea seed, development, root, seedling
201 Diagram of a Simple Leaf blade, axillary bud, stem, petiole, main vein
202 Plant Tissues (simple) epidermal cells, parenchyma, chlorenchyma, sclerenchyma, angular collenchyma, lacunar collenchyma
203 Plant Structure (simplified) vacuole, nucleus, mitochondrions, chloroplasts, ribosomes, cytoplasm, cell wall
204 Illustration of Spirogyra green algae, water silk
205 Spirogyra Life Cycles vegetative filaments, proliferation by fragmentation, conjugation, conjugation tube, protoplast, zygospore, scalariform, reproduction, green algae, water silk
206 Anatomical Illustration of a Sponge spicules, osculum, spongocoel, basal end, radial canal, ovum, choanocyte, pinacocyte, blastula, mesohyl, ostium, porocyte
207 Anatomical Illustration of a Squid ovary, fin, crop, stomact, gill, ink sac, funnel, buccal mass, brain, pen, digestive gland, oviducal gland
208 Experimental Design for Starch: Step 1 hot plate, water, alcohol, beaker, leaf
209 Experimental Design for Starch: Step 2 iodine, leaf, dropper
210 Illustrations of Monocot and Dicot Stems vascular bundle, pith, cortex, epidermis, xylem, phloem, companion cell, ground tissue
211 Anatomical Illustration of a Sunflower:Vascular Bundle xylem, cambium, phloem, cortex, stroma, interfascicular cambium
212 Spirogyra Conjugation reproduction, conjugation tube, gamete, zygospore, male, female, green algae, water silk
213 Illustration of a Tapeworm head, suckers, parasite
214 Experimental Design for Germinating Seeds: Step 1 KOH pellets,cotton, germinating seeds, cellular respiration
215 Experimental Design for Germinating Seeds: Step 2 KOH pellets, cotton, germinating seeds, cellular respiration, pipet, water bath
216 Development of Muscle Cells myoblasts, multiplication, fiber, alignment, fusion
217 Electrocardiogram Output and Voltage QRS Complex, ECG, T wave, U wave, P wave, Voltage, time, ST segment
218 Sarcomere Molecular Organization Z-line, sacromere, muscle fiber, I band, actin, M-line, myosin
219 Seperation of Homologous Chromosomes duplication, replication, chromosomes, meiosis, homologous recombination, offspring cells, daughter nuclei, new genetic material
220 Blepharisma unicellular, ciliate, protist, microbe
221 Anatomical Illustration of a Daphnia carapace, embryo, paired ovary, brood chamber, oviduct, abdominal claw, thoracic appendages, first antenna
222 Diffusion and Osmosis hypertonic, hypotonic, plasmolysis, turgor pressure, water movement
223 DNA Structure
224 Zamia, Life Cycle mature sporophyte, microsporophyl, megasporophyl, gametophyte, sporeling, antherozoid, female cone, male cone, Zamiaceae
225 Leukocyte Rolling, Adhesion,a nd Extravasation leukocyte, rolling, adhesion, extravasation, leukocyte migration, acute imflammatory response, L-selectin, diapedesis, integrin, Sialyl-Lewis, E-selectin, blood vessel wall
226 Antibody Epitope, Heavy chain, Light chain, variable region, constant region
227 Anatomical Illustration of Human Lymphatic System adenoids, appendix, bone marrow, lymph nodes, lymphatic duct, thymus peyer's patches, spleed, intestine, tonsil
228 Types of Cells In the Blood lympocyte, monocyte, neutrophil, red cell, basophil, eosinophil
229 Immumoglobulin Gene Arrangement pro-B cell, pre-B cell, B cell, plasma cell, RAG1, RAG2, V Chain, D Chain, J Chain, C Chain, antibody
230 Areas of Possible Immunodeficiency thymus, bone marrow, periphery, pharyngeal pouches, pre-T, pre-B
231 Activation of Innate and Adaptive Immunity antigen-presenting cell, pathogen, T-cell, MHC class II, CD28, cytokines, toll-like receptor, PAMP
232 Location and Org of the HLA Complex on Chromosome 6 centromere, telomere, class I, class II, class III, human leukocyte, antigen
233 Roles of a Mast Cell in the Immune Cell Mast cell, antigen, skin, ECF-A, eosinophil, histamine, kinins, proteases, vasodilation, edema, bronchospasm, gastroinestinal tract, respiratory tract
234 MHC Class II Co-Dominantly Expressed father, mother, paternal, maternal, haplotype, phenotype
235 Immune Cells Associated With An Oligodendrocyte neuron, axon, myelin sheath, CD4, CD8, gamma delta I cell, NKG2D, NK cell, microglia, astrocyte, IL 15, IL-2
236 Overview of Lymphocyte Responses microbe, dendritic cell, Th2 cell, B cell, foy receptor, interdigitating, follicular, antibody, interleukin, interferon, macrophage, virus, class II MHC, cytotoxic T cell, virus, TCR
237 T-Cell Destinations activated, immunologic ignorance, deletion, inhibition, apoptosis, suppression, IL-10, TGF-B, CD80, peptide, MHC CD3, CD28, antigen presenting cell
238 HLA-Peptide Complex Presentation virus, phagocytosis, viral mRNA, replication, HLA class I molecule, proteosome, exocytosis
239 HLA (MHC II) Peptide Complex Presentation foreign protein, endocytosis, HLA class II molecule, lysosome, endosome, exocytosis, HLA-DM
240 B Cell Recognition of Epitopes on Pathogen clonal proliferation, B cell, pathogen, epitope, B cell receptor
241 Recombination variable domain, constant domain, light chain, heavy chain
242 Structure of HLA Molecules human leukocyte antigen, peptide binding groove, cytoplasmic tail, plasma membrane, transmembrane domain, alpha domain, beta domain, HLA Class I, HLA Class II
243 Germinal Center B cells, lymph node, mantle zone, dark zone, basal light zone, apical zone , follicular dendritic cells, somatic hypermutation, class switching
244 Interdigitating Dendritic Cells dendritic cells, lymph node, T-cell, T-cell receptor, CD28, endogenous activators, B7, MHC-peptide
245 Co-Dominant Expression of MHC Gene Products in Inbred Mice phenotype, hybrid, haplotype, paternal, maternal
246 Illustration of Lymphocyte and Dendritic Cell Interaction lymphocyte, dendritic cell
247 General Baby Venous System Development human development, venous, uterus
248 Blood Pressure Relationship to Blood Vessel Diameter
249 Chick Embryo Labled Diagram: 72 Hours Afer Fertilization brain, eye, heart, wing bud, vitelline vein, vitelline artery, somite, tail bud, hind limb bud, aortic arches, ear, otic vesicle, development, fertilization
250 Cnidaria Life Cycle anthoza, polyp, scyphozoa, medusa, hydrozoa, planula, ephyra, scyphistoma, sexual, asexual, repoduction
251 Cross Section of Maple Wood late wood, early wood
252 Cross Section of Oak Wood late wood, early wood
253 Cross Section of Oine Wood late wood, early wood
254 DNA Replication sugar, phosphate, backbone, adenine, thymine, cytosine, guanine
255 Pine Life Cycle cone, staminate, microsplorophyll, ovulate, megasporophyll, ovule, seedling, winged seed, megagametophyte
256 Anatomical Illustration of a Pine Needle: Cross Section hypodermis, sunken stoma, epidermis, mesophyll, vascular bundles, endodermis, resin duct
257 Plant Cell Cytokinesis mitosis, meiosis, cell plate, golgi vesicles, nucleus
258 Potometer: Experimental Design plant cutting, water, transpiration, evaporation, rate of water uptake
259 Chick Embryo Labeled Diagram: 96 Hours After Fertilization auditory vesicle, ear, aortic arch, auricle, atrium, ventricle, wing bud, vitelline blood vessels, somite, leg bud, allantois, telencephalon, olfactory pit, diencephalon, optic lens, optic cup, mesencephalon, myelencephalon, metencephalon, rhombencephalon
260 Lichen Body Types crustos, foliose, fruticose
261 Dinoflagellates
262 Water Movement in a Tree water potential, gradient, root cells, stem, leaf, cohesion, adhesion, xylem, transpiration, water, mesophyll cells, stoma, water, movement, atmosphere